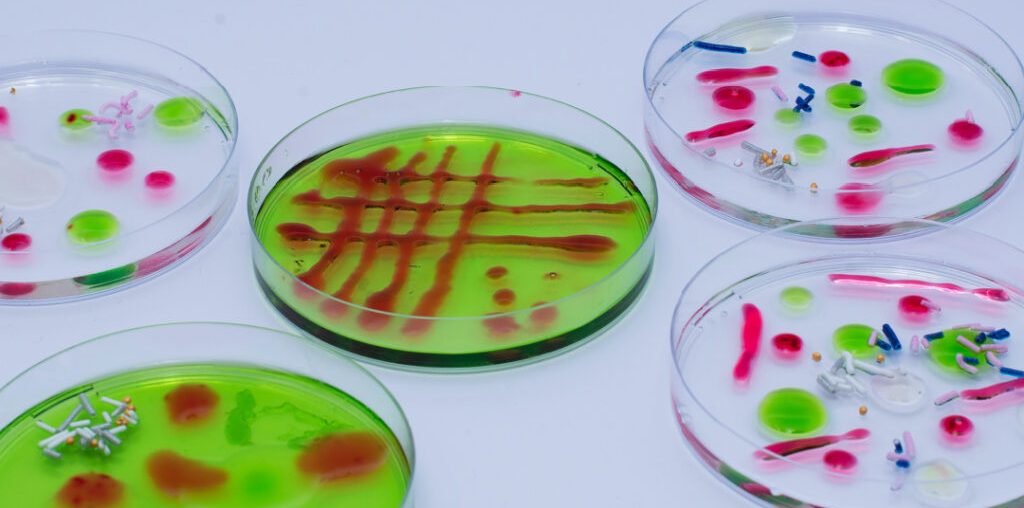

These jelly/jello petri dish bacteria snacks are a fun Halloween party treat or just an unusual way to learn about bacteria!
A petri dish is a shallow, round dish with a loose-fitting lid used to grow bacteria in a laboratory. Microbiologists use them for experiments and investigations. In a laboratory setting, a layer of agar (or another growth medium) is spread over the base of the petri dish. When the agar sets, bacteria and other microorganisms can be grown under controlled conditions.
This activity is not an experiment, and we’re not growing bacteria, it’s just a fun learning activity.
Jello Petri Dish Bacteria
You’ll need
Food grade petri dishes
Unflavoured gelatin powder
Flavoured gelatin powder or jello
Spoon
Jug
Instructions
Wash and dry the petri dishes.
Prepare the unflavored gelatin according to the instructions on the packet. This represents the growth medium.
Allow the mixture to cool slightly, then pour a thin layer into each petri dish. Allow to set completely.
Make the coloured jelly, following the instructions. Use the different colours to add circles and patterns to the clear jelly, resembling bacteria.
Leave to set.
Fun facts about petri dishes
The loose lid prevents contamination while still allowing air flow.
The petri dish was invented by German bacteriologist Julius Richard Petri in 1887.
Petri dishes are used for more than just growing bacteria. They can also be used for growing human and animal cells.
It was a contaminated petri dish that led to the discovery of penicillin by Alexander Fleming in 1928.
More activities for learning about microorganisms
Grow bacteria on potatoes – always dispose of them carefully afterwards.
Find out why it’s important to wash your hands before eating.
Discover how bacteria are different to viruses.
Last Updated on October 9, 2025 by Emma Vanstone
The post Jelly Petri Dish Bacteria appeared first on Science Experiments for Kids.
Science Experiments for Kids Read More